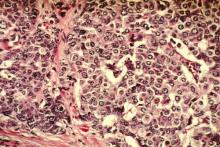

User login
Pictilisib plus fulvestrant boosts PFS in ER/PR+ patients
SAN ANTONIO – The combination of pictilisib and fulvestrant improved progression-free survival in some women with advanced hormone receptor–positive breast cancer – but the jury is out on whether that benefit is clinically meaningful.
At 17 months, women taking the dual regimen were 26% less likely to experience disease progression, but that progression-free survival difference amounted to only about 2 months, Dr. Eric Winer said at the San Antonio Breast Cancer Symposium.
Results were slightly better in those with both progesterone and estrogen receptor–positive tumors, and in the small subgroup of patients with a confirmed PIK3CA mutation tumor, Dr. Winer, a coinvestigator on the study, said during a press briefing.
“There was enough action here that there is interest in pursuing research on this [investigational] drug,” said Dr. Winer of the Dana Farber Cancer Institute, Boston. “Whether or not this is the right drug remains to be seen. ... We will see if there is a stronger signal in the ongoing phase III trial.”
Pictilisib is a PI3 kinase inhibitor, under development by Genentech. PI3 kinase is an oncogene commonly mutated in cancer. The PI3k/Akt/mTOR pathway regulates cell growth and survival. However, pictilisib is a nonselective pan-inhibitor of this pathway, so concern remains about side effects involving normal PI3k processes.
The FERGI study randomized 168 women (89 in the combination arm) with estrogen receptor–positive and/or progesterone receptor–positive tumors to either fulvestrant 500 mg plus placebo or fulvestrant 500 mg plus pictilisib 340 mg. All patients had failed prior treatment with an aromatase inhibitor, relapsing within 6 months of beginning or completing AI treatment, or by having disease progression while on AI treatment. They were stratified by both hormone receptor and PIK3CA tumor status. The study’s primary endpoint was progression-free survival duration in the entire group, and within both subgroups.
Fulvestrant was administered on day 1 of each 28-day cycle and pictilisib or placebo every day. Tumor assessments were performed every 8 weeks of the 24-week trial.
At a mean follow-up of 17 months, 120 patients had progressed – 59 in the combination group and 61 in the placebo group – a nonsignificant difference (P = .096). Time to progression was 6.6 months in the combination arm vs. 5.1 months in the placebo arm.
Combination therapy conferred a significant advantage, however, upon women whose tumors were both ER+ and PR+. Among this group of 116, there were 57 progression events. The median time to progression was significantly longer in the combination arm than in the placebo arm (7.4 months vs. 3.7 months), representing a 56% risk reduction (P = .002).
The combination conferred no survival benefit on women whose tumors were positive for the PIK3CA mutation. “This was a surprise because the PIK3CA gene is a central component of the PI3k signaling pathway. It may be that PIK3CA mutation is not the only way to activate PI3k signaling,” Dr. Winer said.
Adverse events were significantly more common among those taking combination therapy. (31% vs. 20%).
Among these were diarrhea (63% vs. 9%); nausea (48% vs. 19%); rash (43% vs. 6%); fatigue (27% vs. 20%); vomiting (20% vs. 4%); decreased appetite (19% vs. 6%); and hyperglycemia (17% vs. 5%). Dysgeusia occurred in 35% of those in the combination arm and in none of those in the placebo arm. There appeared to be no drug-drug interaction between fulvestrant and pictilisib; there were no treatment-related deaths.
“The bottom line is we had hoped for a somewhat more active improvement seen in progression-free survival, but the exploratory subgroup [of ER+ PR+ tumors] is worth looking into further,” Dr. Winer said.
In an interview, moderator Dr. Jennifer Litton of the University of Texas MD Anderson Cancer Center, Houston, questioned what the statistically significant progression-free survival differences would really mean clinically. By 21 months, the median overall survival difference had declined to 6.6 months vs. 5.1 months for the intention-to-treat group. “You have to wonder if it’s really worth it, considering the side effects.”
At any rate, Dr. Winer wondered aloud if pictilisib has much of a future. While Genentech continues to test the drug in phase III trials, several other PI3k inhibitors are in early studies. These look to be both more effective and more selectively targeted than pictilisib – a combination that would theoretically decrease side effects while improving survival.
“There are more data to be analyzed,” he said. “But I predict that in the wake of these newer drugs, pictilisib will not go forward after they are.”
The study was funded by Genentech. Dr. Winer had no financial disclosures. The principal investigator, Dr. Ian Krop of the Dana-Farber Cancer Institute, receives research funding from the company.
SAN ANTONIO – The combination of pictilisib and fulvestrant improved progression-free survival in some women with advanced hormone receptor–positive breast cancer – but the jury is out on whether that benefit is clinically meaningful.
At 17 months, women taking the dual regimen were 26% less likely to experience disease progression, but that progression-free survival difference amounted to only about 2 months, Dr. Eric Winer said at the San Antonio Breast Cancer Symposium.
Results were slightly better in those with both progesterone and estrogen receptor–positive tumors, and in the small subgroup of patients with a confirmed PIK3CA mutation tumor, Dr. Winer, a coinvestigator on the study, said during a press briefing.
“There was enough action here that there is interest in pursuing research on this [investigational] drug,” said Dr. Winer of the Dana Farber Cancer Institute, Boston. “Whether or not this is the right drug remains to be seen. ... We will see if there is a stronger signal in the ongoing phase III trial.”
Pictilisib is a PI3 kinase inhibitor, under development by Genentech. PI3 kinase is an oncogene commonly mutated in cancer. The PI3k/Akt/mTOR pathway regulates cell growth and survival. However, pictilisib is a nonselective pan-inhibitor of this pathway, so concern remains about side effects involving normal PI3k processes.
The FERGI study randomized 168 women (89 in the combination arm) with estrogen receptor–positive and/or progesterone receptor–positive tumors to either fulvestrant 500 mg plus placebo or fulvestrant 500 mg plus pictilisib 340 mg. All patients had failed prior treatment with an aromatase inhibitor, relapsing within 6 months of beginning or completing AI treatment, or by having disease progression while on AI treatment. They were stratified by both hormone receptor and PIK3CA tumor status. The study’s primary endpoint was progression-free survival duration in the entire group, and within both subgroups.
Fulvestrant was administered on day 1 of each 28-day cycle and pictilisib or placebo every day. Tumor assessments were performed every 8 weeks of the 24-week trial.
At a mean follow-up of 17 months, 120 patients had progressed – 59 in the combination group and 61 in the placebo group – a nonsignificant difference (P = .096). Time to progression was 6.6 months in the combination arm vs. 5.1 months in the placebo arm.
Combination therapy conferred a significant advantage, however, upon women whose tumors were both ER+ and PR+. Among this group of 116, there were 57 progression events. The median time to progression was significantly longer in the combination arm than in the placebo arm (7.4 months vs. 3.7 months), representing a 56% risk reduction (P = .002).
The combination conferred no survival benefit on women whose tumors were positive for the PIK3CA mutation. “This was a surprise because the PIK3CA gene is a central component of the PI3k signaling pathway. It may be that PIK3CA mutation is not the only way to activate PI3k signaling,” Dr. Winer said.
Adverse events were significantly more common among those taking combination therapy. (31% vs. 20%).
Among these were diarrhea (63% vs. 9%); nausea (48% vs. 19%); rash (43% vs. 6%); fatigue (27% vs. 20%); vomiting (20% vs. 4%); decreased appetite (19% vs. 6%); and hyperglycemia (17% vs. 5%). Dysgeusia occurred in 35% of those in the combination arm and in none of those in the placebo arm. There appeared to be no drug-drug interaction between fulvestrant and pictilisib; there were no treatment-related deaths.
“The bottom line is we had hoped for a somewhat more active improvement seen in progression-free survival, but the exploratory subgroup [of ER+ PR+ tumors] is worth looking into further,” Dr. Winer said.
In an interview, moderator Dr. Jennifer Litton of the University of Texas MD Anderson Cancer Center, Houston, questioned what the statistically significant progression-free survival differences would really mean clinically. By 21 months, the median overall survival difference had declined to 6.6 months vs. 5.1 months for the intention-to-treat group. “You have to wonder if it’s really worth it, considering the side effects.”
At any rate, Dr. Winer wondered aloud if pictilisib has much of a future. While Genentech continues to test the drug in phase III trials, several other PI3k inhibitors are in early studies. These look to be both more effective and more selectively targeted than pictilisib – a combination that would theoretically decrease side effects while improving survival.
“There are more data to be analyzed,” he said. “But I predict that in the wake of these newer drugs, pictilisib will not go forward after they are.”
The study was funded by Genentech. Dr. Winer had no financial disclosures. The principal investigator, Dr. Ian Krop of the Dana-Farber Cancer Institute, receives research funding from the company.
SAN ANTONIO – The combination of pictilisib and fulvestrant improved progression-free survival in some women with advanced hormone receptor–positive breast cancer – but the jury is out on whether that benefit is clinically meaningful.
At 17 months, women taking the dual regimen were 26% less likely to experience disease progression, but that progression-free survival difference amounted to only about 2 months, Dr. Eric Winer said at the San Antonio Breast Cancer Symposium.
Results were slightly better in those with both progesterone and estrogen receptor–positive tumors, and in the small subgroup of patients with a confirmed PIK3CA mutation tumor, Dr. Winer, a coinvestigator on the study, said during a press briefing.
“There was enough action here that there is interest in pursuing research on this [investigational] drug,” said Dr. Winer of the Dana Farber Cancer Institute, Boston. “Whether or not this is the right drug remains to be seen. ... We will see if there is a stronger signal in the ongoing phase III trial.”
Pictilisib is a PI3 kinase inhibitor, under development by Genentech. PI3 kinase is an oncogene commonly mutated in cancer. The PI3k/Akt/mTOR pathway regulates cell growth and survival. However, pictilisib is a nonselective pan-inhibitor of this pathway, so concern remains about side effects involving normal PI3k processes.
The FERGI study randomized 168 women (89 in the combination arm) with estrogen receptor–positive and/or progesterone receptor–positive tumors to either fulvestrant 500 mg plus placebo or fulvestrant 500 mg plus pictilisib 340 mg. All patients had failed prior treatment with an aromatase inhibitor, relapsing within 6 months of beginning or completing AI treatment, or by having disease progression while on AI treatment. They were stratified by both hormone receptor and PIK3CA tumor status. The study’s primary endpoint was progression-free survival duration in the entire group, and within both subgroups.
Fulvestrant was administered on day 1 of each 28-day cycle and pictilisib or placebo every day. Tumor assessments were performed every 8 weeks of the 24-week trial.
At a mean follow-up of 17 months, 120 patients had progressed – 59 in the combination group and 61 in the placebo group – a nonsignificant difference (P = .096). Time to progression was 6.6 months in the combination arm vs. 5.1 months in the placebo arm.
Combination therapy conferred a significant advantage, however, upon women whose tumors were both ER+ and PR+. Among this group of 116, there were 57 progression events. The median time to progression was significantly longer in the combination arm than in the placebo arm (7.4 months vs. 3.7 months), representing a 56% risk reduction (P = .002).
The combination conferred no survival benefit on women whose tumors were positive for the PIK3CA mutation. “This was a surprise because the PIK3CA gene is a central component of the PI3k signaling pathway. It may be that PIK3CA mutation is not the only way to activate PI3k signaling,” Dr. Winer said.
Adverse events were significantly more common among those taking combination therapy. (31% vs. 20%).
Among these were diarrhea (63% vs. 9%); nausea (48% vs. 19%); rash (43% vs. 6%); fatigue (27% vs. 20%); vomiting (20% vs. 4%); decreased appetite (19% vs. 6%); and hyperglycemia (17% vs. 5%). Dysgeusia occurred in 35% of those in the combination arm and in none of those in the placebo arm. There appeared to be no drug-drug interaction between fulvestrant and pictilisib; there were no treatment-related deaths.
“The bottom line is we had hoped for a somewhat more active improvement seen in progression-free survival, but the exploratory subgroup [of ER+ PR+ tumors] is worth looking into further,” Dr. Winer said.
In an interview, moderator Dr. Jennifer Litton of the University of Texas MD Anderson Cancer Center, Houston, questioned what the statistically significant progression-free survival differences would really mean clinically. By 21 months, the median overall survival difference had declined to 6.6 months vs. 5.1 months for the intention-to-treat group. “You have to wonder if it’s really worth it, considering the side effects.”
At any rate, Dr. Winer wondered aloud if pictilisib has much of a future. While Genentech continues to test the drug in phase III trials, several other PI3k inhibitors are in early studies. These look to be both more effective and more selectively targeted than pictilisib – a combination that would theoretically decrease side effects while improving survival.
“There are more data to be analyzed,” he said. “But I predict that in the wake of these newer drugs, pictilisib will not go forward after they are.”
The study was funded by Genentech. Dr. Winer had no financial disclosures. The principal investigator, Dr. Ian Krop of the Dana-Farber Cancer Institute, receives research funding from the company.
AT SABCS 2014
Key clinical point: The combination of fulvestrant and the investigational PI3 kinase inhibitor pictilisib conferred a significant progression-free survival advantage on women with ER+ PR+ breast cancers, but none upon those with only ER+ tumors.
Major finding: Among the double-positive women, progression-free survival time was 7.4 months in the combination group vs. 3.7 months in the placebo group.
Data source: The randomized, placebo-controlled, phase II trial comprised 168 patients.
Disclosures:The study was funded by Genentech. Dr. Winer had no financial disclosures. The principal investigator, Dr. Ian Krop of the Dana-Farber Cancer Institute, receives research funding from the company.
Ultrasound screening for dense breasts is high cost, offers little benefit
Supplemental screening ultrasonography would add substantial costs while providing little clinical benefit after a negative screening mammography in women with dense breasts, according to three validated microsimulation models.
Adding ultrasound screening after a negative mammogram for women with heterogeneously or extremely dense breasts would cost more than $100,000 per quality-adjusted life-years (QALY) gained, compared with mammography screening alone, the models consistently showed.
Using simulated cohorts of women aged 50-74 years who were undergoing biennial mammography screening, the three models yielded similar results with respect to the estimated benefits and harms of three screening strategies: mammography alone, mammography plus screening ultrasonography after a negative mammography result in women with extremely dense breasts, and mammography plus handheld screening ultrasonography after a negative mammography result in women with heterogeneously or extremely dense breasts.
Brian L. Sprague, Ph.D., of the University of Vermont, Burlington, and his colleagues reported the findings in the Dec. 9 edition of Annals of Internal Medicine.
The findings could help influence the current national debate over breast density notification laws. At least 19 states have already enacted legislation that requires that women with dense breasts be informed about their breast density and about the availability of supplemental screening tests such as ultrasound. The high rate of false-negative mammograms in women with dense breasts is driving patient advocates to seek similar laws across the country. There’s even a bill under consideration at the national level.
The researchers found that mammography screening alone, across the models, reduced breast cancer deaths from 25.4 per 1,000 women in the absence of screening, to 19.7 per 1,000 women. There was an increase in total costs of approximately $1 million per 1,000 women.
Compared with biennial mammography screening alone, supplemental screening ultrasonography for women with extremely dense breasts would avert 0.30 additional breast cancer deaths and produce 1.1 additional QALY per 1,000 women, or about 9.6 hours per woman. These gains would come at a cost of 189 biopsies resulting from false-positive findings and $287,000 per 1,000 women with extremely dense breasts (a cost-effectiveness ratio of $246,000 per QALY gained).
In women with heterogeneously or extremely dense breasts, supplemental ultrasonography would avert 0.36 additional breast cancer deaths and produce 1.7 additional QALYs per 1,000 women. But these benefits would come at a cost of 354 biopsies resulting from a false-positive finding, and $560,000 per 1,000 women with heterogeneously or extremely dense breasts (a cost effectiveness ratio of $325,000/QALY gained), according to the study.
Restricting supplemental screening ultrasonography only to those with extremely dense breasts improved efficiency somewhat, but even this approach was not cost-effective by most standards.
The study used established, validated Cancer Intervention and Surveillance Modeling Network microsimulation breast cancer models, which incorporate evidence from clinical trials and observational studies.
“The models simulated life histories of women who were at risk for breast cancer, had screening, were treated for breast cancer diagnosed by screening or clinical detection, and were at risk for dying of breast cancer and other causes,” the researchers wrote, adding that the models differed in structure, but used common inputs.
The researchers called for further studies evaluating the potential role of other imaging methods, such as magnetic resonance imaging and digital breast tomosynthesis, in screening for women with dense breasts.
This study was funded by the National Cancer Institute. Dr. Sprague and several of the study authors reported receiving grant funds from the National Cancer Institute during the conduct of the study.
Supplemental screening ultrasonography would add substantial costs while providing little clinical benefit after a negative screening mammography in women with dense breasts, according to three validated microsimulation models.
Adding ultrasound screening after a negative mammogram for women with heterogeneously or extremely dense breasts would cost more than $100,000 per quality-adjusted life-years (QALY) gained, compared with mammography screening alone, the models consistently showed.
Using simulated cohorts of women aged 50-74 years who were undergoing biennial mammography screening, the three models yielded similar results with respect to the estimated benefits and harms of three screening strategies: mammography alone, mammography plus screening ultrasonography after a negative mammography result in women with extremely dense breasts, and mammography plus handheld screening ultrasonography after a negative mammography result in women with heterogeneously or extremely dense breasts.
Brian L. Sprague, Ph.D., of the University of Vermont, Burlington, and his colleagues reported the findings in the Dec. 9 edition of Annals of Internal Medicine.
The findings could help influence the current national debate over breast density notification laws. At least 19 states have already enacted legislation that requires that women with dense breasts be informed about their breast density and about the availability of supplemental screening tests such as ultrasound. The high rate of false-negative mammograms in women with dense breasts is driving patient advocates to seek similar laws across the country. There’s even a bill under consideration at the national level.
The researchers found that mammography screening alone, across the models, reduced breast cancer deaths from 25.4 per 1,000 women in the absence of screening, to 19.7 per 1,000 women. There was an increase in total costs of approximately $1 million per 1,000 women.
Compared with biennial mammography screening alone, supplemental screening ultrasonography for women with extremely dense breasts would avert 0.30 additional breast cancer deaths and produce 1.1 additional QALY per 1,000 women, or about 9.6 hours per woman. These gains would come at a cost of 189 biopsies resulting from false-positive findings and $287,000 per 1,000 women with extremely dense breasts (a cost-effectiveness ratio of $246,000 per QALY gained).
In women with heterogeneously or extremely dense breasts, supplemental ultrasonography would avert 0.36 additional breast cancer deaths and produce 1.7 additional QALYs per 1,000 women. But these benefits would come at a cost of 354 biopsies resulting from a false-positive finding, and $560,000 per 1,000 women with heterogeneously or extremely dense breasts (a cost effectiveness ratio of $325,000/QALY gained), according to the study.
Restricting supplemental screening ultrasonography only to those with extremely dense breasts improved efficiency somewhat, but even this approach was not cost-effective by most standards.
The study used established, validated Cancer Intervention and Surveillance Modeling Network microsimulation breast cancer models, which incorporate evidence from clinical trials and observational studies.
“The models simulated life histories of women who were at risk for breast cancer, had screening, were treated for breast cancer diagnosed by screening or clinical detection, and were at risk for dying of breast cancer and other causes,” the researchers wrote, adding that the models differed in structure, but used common inputs.
The researchers called for further studies evaluating the potential role of other imaging methods, such as magnetic resonance imaging and digital breast tomosynthesis, in screening for women with dense breasts.
This study was funded by the National Cancer Institute. Dr. Sprague and several of the study authors reported receiving grant funds from the National Cancer Institute during the conduct of the study.
Supplemental screening ultrasonography would add substantial costs while providing little clinical benefit after a negative screening mammography in women with dense breasts, according to three validated microsimulation models.
Adding ultrasound screening after a negative mammogram for women with heterogeneously or extremely dense breasts would cost more than $100,000 per quality-adjusted life-years (QALY) gained, compared with mammography screening alone, the models consistently showed.
Using simulated cohorts of women aged 50-74 years who were undergoing biennial mammography screening, the three models yielded similar results with respect to the estimated benefits and harms of three screening strategies: mammography alone, mammography plus screening ultrasonography after a negative mammography result in women with extremely dense breasts, and mammography plus handheld screening ultrasonography after a negative mammography result in women with heterogeneously or extremely dense breasts.
Brian L. Sprague, Ph.D., of the University of Vermont, Burlington, and his colleagues reported the findings in the Dec. 9 edition of Annals of Internal Medicine.
The findings could help influence the current national debate over breast density notification laws. At least 19 states have already enacted legislation that requires that women with dense breasts be informed about their breast density and about the availability of supplemental screening tests such as ultrasound. The high rate of false-negative mammograms in women with dense breasts is driving patient advocates to seek similar laws across the country. There’s even a bill under consideration at the national level.
The researchers found that mammography screening alone, across the models, reduced breast cancer deaths from 25.4 per 1,000 women in the absence of screening, to 19.7 per 1,000 women. There was an increase in total costs of approximately $1 million per 1,000 women.
Compared with biennial mammography screening alone, supplemental screening ultrasonography for women with extremely dense breasts would avert 0.30 additional breast cancer deaths and produce 1.1 additional QALY per 1,000 women, or about 9.6 hours per woman. These gains would come at a cost of 189 biopsies resulting from false-positive findings and $287,000 per 1,000 women with extremely dense breasts (a cost-effectiveness ratio of $246,000 per QALY gained).
In women with heterogeneously or extremely dense breasts, supplemental ultrasonography would avert 0.36 additional breast cancer deaths and produce 1.7 additional QALYs per 1,000 women. But these benefits would come at a cost of 354 biopsies resulting from a false-positive finding, and $560,000 per 1,000 women with heterogeneously or extremely dense breasts (a cost effectiveness ratio of $325,000/QALY gained), according to the study.
Restricting supplemental screening ultrasonography only to those with extremely dense breasts improved efficiency somewhat, but even this approach was not cost-effective by most standards.
The study used established, validated Cancer Intervention and Surveillance Modeling Network microsimulation breast cancer models, which incorporate evidence from clinical trials and observational studies.
“The models simulated life histories of women who were at risk for breast cancer, had screening, were treated for breast cancer diagnosed by screening or clinical detection, and were at risk for dying of breast cancer and other causes,” the researchers wrote, adding that the models differed in structure, but used common inputs.
The researchers called for further studies evaluating the potential role of other imaging methods, such as magnetic resonance imaging and digital breast tomosynthesis, in screening for women with dense breasts.
This study was funded by the National Cancer Institute. Dr. Sprague and several of the study authors reported receiving grant funds from the National Cancer Institute during the conduct of the study.
Key clinical point: Screening ultrasonography after a negative mammogram would significantly increase costs without providing much benefit for women with dense breasts.
Major finding: The overall cost-effectiveness ratio was $325,000 per quality-adjusted life-years gained in women with heterogeneously or extremely dense breasts.
Data source: Three microsimulation models developed within the Cancer Intervention and Surveillance Modeling Network consortium.
Disclosures: The study was funded by the National Cancer Institute. Dr. Sprague and several study authors reported receiving grant funds from the National Cancer Institute during the conduct of the study.
Too many elderly with breast cancer still receive radiotherapy
The use of adjuvant radiotherapy in elderly women with early-stage breast cancer has declined since the publication of study results showing that lumpectomy and tamoxifen therapy were preferable to radiotherapy in this patient group, but nearly two-thirds of these women continue to receive adjuvant radiotherapy, according to analysis of data from the Surveillance, Epidemiology, and End Results registry.
SEER data from 40,583 women showed that, between 2000 and 2004, 68.6% of eligible patients –women aged over 70 years with stage 1, estrogen receptor–positive breast cancer – received adjuvant radiotherapy, but this declined to 61.7% of patients between 2005 and 2009, representing a small but statistically significant decline.
Radiotherapy use declined significantly across all age groups, tumor sizes, and grades, regardless of laterality, although it was used slightly less frequently in patients aged over 85, compared with those aged 70-74 years, according to a study published online Dec. 8 (Cancer 2014 [doi:10.1002/cncr.28937].
“Data supporting the omission of radiotherapy in elderly patients has emerged simultaneously with promising long-term results from partial breast irradiation trials and data demonstrating the equal efficacy of conventionally fractionated whole-breast radiotherapy compared with more hypofractionated whole-breast regimens,” wrote Dr. Manisha Palta of Duke University, Durham, N.C., and her colleagues.
“These data may partially explain why older women continue to be offered and receive adjuvant radiotherapy,” they said.
Additional reasons why data from randomized trials may not be incorporated into clinical practice could include financial incentives and the fact that “the medical community may react differently to withholding treatment compared with adding a new treatment,” Dr. Palta and her colleagues said.
There were no conflicts of interest declared.
The use of adjuvant radiotherapy in elderly women with early-stage breast cancer has declined since the publication of study results showing that lumpectomy and tamoxifen therapy were preferable to radiotherapy in this patient group, but nearly two-thirds of these women continue to receive adjuvant radiotherapy, according to analysis of data from the Surveillance, Epidemiology, and End Results registry.
SEER data from 40,583 women showed that, between 2000 and 2004, 68.6% of eligible patients –women aged over 70 years with stage 1, estrogen receptor–positive breast cancer – received adjuvant radiotherapy, but this declined to 61.7% of patients between 2005 and 2009, representing a small but statistically significant decline.
Radiotherapy use declined significantly across all age groups, tumor sizes, and grades, regardless of laterality, although it was used slightly less frequently in patients aged over 85, compared with those aged 70-74 years, according to a study published online Dec. 8 (Cancer 2014 [doi:10.1002/cncr.28937].
“Data supporting the omission of radiotherapy in elderly patients has emerged simultaneously with promising long-term results from partial breast irradiation trials and data demonstrating the equal efficacy of conventionally fractionated whole-breast radiotherapy compared with more hypofractionated whole-breast regimens,” wrote Dr. Manisha Palta of Duke University, Durham, N.C., and her colleagues.
“These data may partially explain why older women continue to be offered and receive adjuvant radiotherapy,” they said.
Additional reasons why data from randomized trials may not be incorporated into clinical practice could include financial incentives and the fact that “the medical community may react differently to withholding treatment compared with adding a new treatment,” Dr. Palta and her colleagues said.
There were no conflicts of interest declared.
The use of adjuvant radiotherapy in elderly women with early-stage breast cancer has declined since the publication of study results showing that lumpectomy and tamoxifen therapy were preferable to radiotherapy in this patient group, but nearly two-thirds of these women continue to receive adjuvant radiotherapy, according to analysis of data from the Surveillance, Epidemiology, and End Results registry.
SEER data from 40,583 women showed that, between 2000 and 2004, 68.6% of eligible patients –women aged over 70 years with stage 1, estrogen receptor–positive breast cancer – received adjuvant radiotherapy, but this declined to 61.7% of patients between 2005 and 2009, representing a small but statistically significant decline.
Radiotherapy use declined significantly across all age groups, tumor sizes, and grades, regardless of laterality, although it was used slightly less frequently in patients aged over 85, compared with those aged 70-74 years, according to a study published online Dec. 8 (Cancer 2014 [doi:10.1002/cncr.28937].
“Data supporting the omission of radiotherapy in elderly patients has emerged simultaneously with promising long-term results from partial breast irradiation trials and data demonstrating the equal efficacy of conventionally fractionated whole-breast radiotherapy compared with more hypofractionated whole-breast regimens,” wrote Dr. Manisha Palta of Duke University, Durham, N.C., and her colleagues.
“These data may partially explain why older women continue to be offered and receive adjuvant radiotherapy,” they said.
Additional reasons why data from randomized trials may not be incorporated into clinical practice could include financial incentives and the fact that “the medical community may react differently to withholding treatment compared with adding a new treatment,” Dr. Palta and her colleagues said.
There were no conflicts of interest declared.
FROM CANCER
Key clinical point: The use of adjuvant radiotherapy has declined over the past decade in elderly patients with early-stage breast cancer, but the rate is still high.
Major finding: Use of adjuvant radiotherapy has declined from 68.6% of eligible patients in 2000-2004 to 61.7% in 2005-2009.
Data source: Retrospective analysis of data from 40,583 women in the SEER registry.
Disclosures: No conflicts of interested were declared.
SABCS 2014: Dr. Hope S. Rugo gives her top picks
S3-01. The TNT trial: A randomized phase III trial of carboplatin (C) compared with docetaxel (D) for patients with metastatic or recurrent locally advanced triple negative or BRCA1/2 breast cancer (CRUK/07/012)
Tutt A et al.
S3-08. Randomized comparison of adjuvant tamoxifen (T) plus ovarian function suppression (OFS) versus tamoxifen in premenopausal women with hormone receptor–positive (HR+) early breast cancer (BC): Analysis of the SOFT trial
Francis PA et al.
S3-09. Patient-reported endocrine symptoms, sexual functioning and quality of life (QoL) in the IBCSG SOFT trial: Adjuvant treatment with tamoxifen (T) alone versus tamoxifen plus ovarian function suppression (OFS) in premenopausal women with hormone receptor–positive (HR+) breast cancer (BC)
Ribi K et al.
S6-01. Phase 3, randomized, double-blind, placebo-controlled multicenter trial of daily everolimus plus weekly trastuzumab and paclitaxel as first-line therapy in women with HER2+ advanced breast cancer: BOLERO-1
Hurvitz SA et al.
S1-09. A phase Ib study of pembrolizumab (MK-3475) in patients with advanced triple-negative breast cancer
Nanda R et al.
Dr. Hope S. Rugo is professor of medicine, University of California, San Francisco, and director, breast oncology and clinical trials education, UCSF Helen Diller Family Comprehensive Cancer Center.
S3-01. The TNT trial: A randomized phase III trial of carboplatin (C) compared with docetaxel (D) for patients with metastatic or recurrent locally advanced triple negative or BRCA1/2 breast cancer (CRUK/07/012)
Tutt A et al.
S3-08. Randomized comparison of adjuvant tamoxifen (T) plus ovarian function suppression (OFS) versus tamoxifen in premenopausal women with hormone receptor–positive (HR+) early breast cancer (BC): Analysis of the SOFT trial
Francis PA et al.
S3-09. Patient-reported endocrine symptoms, sexual functioning and quality of life (QoL) in the IBCSG SOFT trial: Adjuvant treatment with tamoxifen (T) alone versus tamoxifen plus ovarian function suppression (OFS) in premenopausal women with hormone receptor–positive (HR+) breast cancer (BC)
Ribi K et al.
S6-01. Phase 3, randomized, double-blind, placebo-controlled multicenter trial of daily everolimus plus weekly trastuzumab and paclitaxel as first-line therapy in women with HER2+ advanced breast cancer: BOLERO-1
Hurvitz SA et al.
S1-09. A phase Ib study of pembrolizumab (MK-3475) in patients with advanced triple-negative breast cancer
Nanda R et al.
Dr. Hope S. Rugo is professor of medicine, University of California, San Francisco, and director, breast oncology and clinical trials education, UCSF Helen Diller Family Comprehensive Cancer Center.
S3-01. The TNT trial: A randomized phase III trial of carboplatin (C) compared with docetaxel (D) for patients with metastatic or recurrent locally advanced triple negative or BRCA1/2 breast cancer (CRUK/07/012)
Tutt A et al.
S3-08. Randomized comparison of adjuvant tamoxifen (T) plus ovarian function suppression (OFS) versus tamoxifen in premenopausal women with hormone receptor–positive (HR+) early breast cancer (BC): Analysis of the SOFT trial
Francis PA et al.
S3-09. Patient-reported endocrine symptoms, sexual functioning and quality of life (QoL) in the IBCSG SOFT trial: Adjuvant treatment with tamoxifen (T) alone versus tamoxifen plus ovarian function suppression (OFS) in premenopausal women with hormone receptor–positive (HR+) breast cancer (BC)
Ribi K et al.
S6-01. Phase 3, randomized, double-blind, placebo-controlled multicenter trial of daily everolimus plus weekly trastuzumab and paclitaxel as first-line therapy in women with HER2+ advanced breast cancer: BOLERO-1
Hurvitz SA et al.
S1-09. A phase Ib study of pembrolizumab (MK-3475) in patients with advanced triple-negative breast cancer
Nanda R et al.
Dr. Hope S. Rugo is professor of medicine, University of California, San Francisco, and director, breast oncology and clinical trials education, UCSF Helen Diller Family Comprehensive Cancer Center.
FROM THE SAN ANTONIO BREAST CANCER SYMPOSIUM
Breast cancer relapse risk halved since 1986
Breast cancer outcomes have improved significantly over the past 3 decades, with major gains in relapse-free survival and declines in mortality for all subtypes but particularly HER-2 positive breast cancer, a retrospective case-control study has found.
Researchers compared matched data from 7,178 women referred to the British Columbia Cancer Agency for breast cancer between 1986 and 1992 (C1) and mid-2004 and 2008 (C2) and found the risk of relapse halved in the second cohort, compared to the first, up to year 7 of follow-up, according to a paper published online Nov. 24 in the Journal of Clinical Oncology [doi:10.1200/JCO.2014.57.2461].
While there were similar patterns of disease relapse over time for both the estrogen receptor (ER)-negative and ER-positive patients between the two cohorts, the risk of relapse halved for ER-negative patients in the second cohort relative to the first, while the risk ratio for C2/C1 ranged from 0.26 to 0.56 in ER-positive patients.
“The greatest improvements in outcomes were achieved in the BC subtypes known to be more aggressive, namely the HER2-positive and ER-negative/HER2-negative patients,” wrote Dr. Rachel J.D. Cossetti and colleagues from the Vancouver (B.C.) Cancer Centre.The study was supported by coauthor Dr. Karen A. Gelmon, also of the Vancouver Cancer Centre.
Breast cancer outcomes have improved significantly over the past 3 decades, with major gains in relapse-free survival and declines in mortality for all subtypes but particularly HER-2 positive breast cancer, a retrospective case-control study has found.
Researchers compared matched data from 7,178 women referred to the British Columbia Cancer Agency for breast cancer between 1986 and 1992 (C1) and mid-2004 and 2008 (C2) and found the risk of relapse halved in the second cohort, compared to the first, up to year 7 of follow-up, according to a paper published online Nov. 24 in the Journal of Clinical Oncology [doi:10.1200/JCO.2014.57.2461].
While there were similar patterns of disease relapse over time for both the estrogen receptor (ER)-negative and ER-positive patients between the two cohorts, the risk of relapse halved for ER-negative patients in the second cohort relative to the first, while the risk ratio for C2/C1 ranged from 0.26 to 0.56 in ER-positive patients.
“The greatest improvements in outcomes were achieved in the BC subtypes known to be more aggressive, namely the HER2-positive and ER-negative/HER2-negative patients,” wrote Dr. Rachel J.D. Cossetti and colleagues from the Vancouver (B.C.) Cancer Centre.The study was supported by coauthor Dr. Karen A. Gelmon, also of the Vancouver Cancer Centre.
Breast cancer outcomes have improved significantly over the past 3 decades, with major gains in relapse-free survival and declines in mortality for all subtypes but particularly HER-2 positive breast cancer, a retrospective case-control study has found.
Researchers compared matched data from 7,178 women referred to the British Columbia Cancer Agency for breast cancer between 1986 and 1992 (C1) and mid-2004 and 2008 (C2) and found the risk of relapse halved in the second cohort, compared to the first, up to year 7 of follow-up, according to a paper published online Nov. 24 in the Journal of Clinical Oncology [doi:10.1200/JCO.2014.57.2461].
While there were similar patterns of disease relapse over time for both the estrogen receptor (ER)-negative and ER-positive patients between the two cohorts, the risk of relapse halved for ER-negative patients in the second cohort relative to the first, while the risk ratio for C2/C1 ranged from 0.26 to 0.56 in ER-positive patients.
“The greatest improvements in outcomes were achieved in the BC subtypes known to be more aggressive, namely the HER2-positive and ER-negative/HER2-negative patients,” wrote Dr. Rachel J.D. Cossetti and colleagues from the Vancouver (B.C.) Cancer Centre.The study was supported by coauthor Dr. Karen A. Gelmon, also of the Vancouver Cancer Centre.
FROM JOURNAL OF CLINICAL ONCOLOGY
Key clinical point: Breast cancer outcomes have improved significantly over the past 3 decades, with major gains in relapse-free survival and declines in mortality for all subtypes.
Major finding: The risk of relapse has halved for estrogen receptor–negative breast cancer since 1986.
Data source: Retrospective matched cohort study of 7178 women with breast cancer.
Disclosures: The study was supported by author Dr. Karen A. Gelmon.
Mastectomies, reconstruction, on the rise for women with early stage disease
Significant increases in the mastectomy rate among women with early breast cancer who were candidates for breast conservation surgery during a recent 14-year period in the United States were accompanied by increases in breast reconstruction and bilateral mastectomies, in a retrospective cohort study that tracked national trends in this group of women.
The results, based on outcomes of about 1.2 million women with early breast cancer in a national oncology outcomes database, “are generally consistent with trends noted in other state, regional, and national studies,” reported Dr. Kristy Kummerow of the division of surgical oncology and endocrine surgery, Vanderbilt University, Nashville, Tenn., and her associates. While they speculated on some of the reasons behind these findings, “further research is needed to understand patient, provider, policy, and social factors associated with these trends,” they concluded in the study, which was published online Nov. 19 in JAMA Surgery (doi:10.1001/jamasurg.2014.2895).
While the use of breast conservation surgery (BCS) as an alternative to mastectomy for early-stage breast cancer increased steadily after studies showed the two approaches had equal outcomes, and after endorsement by a National Institutes of Health Consensus Conference in 1990, the authors noted that there has been evidence that the trend is reversing.
Using data from the National Cancer Data Base, which collects outcomes data on about 70% of the patients diagnosed with cancer in the United States, they evaluated trends in mastectomies among adult women newly diagnosed with early (unilateral) breast cancer from January 1998 through December 2011. Women were included if TNM stage information was available, tumors were 5 cm or less with nine or fewer involved axillary lymph nodes based on clinical staging, and they underwent BCS (lumpectomy, segmental mastectomy, or re-excision of the biopsy site) or mastectomy (subcutaneous, total, modified radical or radical).
Over the 14-year period, among the approximately 1.2 million women who met the criteria, 64.5% had BCS and 35.5% had a mastectomy. The women who had a mastectomy were slightly younger (mean age 59.6 years vs. 61.6 years), and the proportion of racial and ethnic minorities was lower in this group.
The proportion of women eligible for BCS who underwent a mastectomy increased from 34.3% in 1998 to 37.8% in 2011, a statistically significant increase, “with steeper increases” seen in women who had node-negative and noninvasive disease, the authors reported. For the most recent 8-year period – 2003 to 2011 – the rate increased by 34%, “with the most notable rise in mastectomy rates occurring after 2006,” and the highest increases seen among women with clinically node-negative disease. Age and tumor size were “the most influential covariates,” with younger women “more likely to undergo mastectomy irrespective of tumor size, while in older women mastectomy was strongly associated with tumor size greater than 2 cm.”
During the period studied, there were significant increases in breast reconstruction and bilateral mastectomies among women who had mastectomies, which were secondary outcome measures. The proportion of women who underwent breast reconstruction increased from 11.6% in 1998 to 36.4% in 2011, and the proportion of women who had a bilateral mastectomy for unilateral disease increased from 1.9% to 11.2% during this period. The trend toward more reconstruction surgery could be due to 1998 legislation mandating insurance coverage of reconstructive surgery after mastectomy, the authors wrote.
Study limitations included missing clinical staging information for a large proportion of the women, no information on BRCA status or triple-negative tumors, and an inability to determine why the mastectomy was performed in individual cases, they noted.
None of the authors had disclosures to report. The study is based on work supported by the Office of Academic Affiliations, Department of Veterans Affairs, the VA National Quality Scholars Program, and with the use of facilities at the VA Tennessee Valley Healthcare System, Nashville.
In an accompanying editorial, Dr. Bonnie Sun and Dr. Michael Zenilman wrote that the “surprising rise” in the mastectomy rate for women with early stage breast cancers in this study raises various questions, including whether all the patients were candidates for BCS, which is difficult to determine “without accounting for findings on magnetic resonance imaging, family history, clinical stage, and tumor to breast ratio.” Another question is why the women chose a mastectomy and whether the reasons for that choice were valid. “While the choice to pursue mastectomy over BCS is never wrong, it must be made for the right reasons,” they said, adding, “when presenting these surgical options, we must ensure that decisions are not based on misconceptions.” This study “ should at least serve as a wake-up call that as we fulfill that responsibility, and use every modality of care to give patients the best quality of life and survival advantage, the guidelines may need to change again,” they wrote (JAMA Surgery 2014 Nov. 19 [doi:10.1001/jamasurg.2014.2902)].
Dr. Bonnie Sun and Dr. Michael E. Zenilman are in the department of surgery, Johns Hopkins Medicine, Bethesda, Md. Dr. Zenilman is a consultant for Champions in Oncology; Dr. Sun had no disclosures to report.
In an accompanying editorial, Dr. Bonnie Sun and Dr. Michael Zenilman wrote that the “surprising rise” in the mastectomy rate for women with early stage breast cancers in this study raises various questions, including whether all the patients were candidates for BCS, which is difficult to determine “without accounting for findings on magnetic resonance imaging, family history, clinical stage, and tumor to breast ratio.” Another question is why the women chose a mastectomy and whether the reasons for that choice were valid. “While the choice to pursue mastectomy over BCS is never wrong, it must be made for the right reasons,” they said, adding, “when presenting these surgical options, we must ensure that decisions are not based on misconceptions.” This study “ should at least serve as a wake-up call that as we fulfill that responsibility, and use every modality of care to give patients the best quality of life and survival advantage, the guidelines may need to change again,” they wrote (JAMA Surgery 2014 Nov. 19 [doi:10.1001/jamasurg.2014.2902)].
Dr. Bonnie Sun and Dr. Michael E. Zenilman are in the department of surgery, Johns Hopkins Medicine, Bethesda, Md. Dr. Zenilman is a consultant for Champions in Oncology; Dr. Sun had no disclosures to report.
In an accompanying editorial, Dr. Bonnie Sun and Dr. Michael Zenilman wrote that the “surprising rise” in the mastectomy rate for women with early stage breast cancers in this study raises various questions, including whether all the patients were candidates for BCS, which is difficult to determine “without accounting for findings on magnetic resonance imaging, family history, clinical stage, and tumor to breast ratio.” Another question is why the women chose a mastectomy and whether the reasons for that choice were valid. “While the choice to pursue mastectomy over BCS is never wrong, it must be made for the right reasons,” they said, adding, “when presenting these surgical options, we must ensure that decisions are not based on misconceptions.” This study “ should at least serve as a wake-up call that as we fulfill that responsibility, and use every modality of care to give patients the best quality of life and survival advantage, the guidelines may need to change again,” they wrote (JAMA Surgery 2014 Nov. 19 [doi:10.1001/jamasurg.2014.2902)].
Dr. Bonnie Sun and Dr. Michael E. Zenilman are in the department of surgery, Johns Hopkins Medicine, Bethesda, Md. Dr. Zenilman is a consultant for Champions in Oncology; Dr. Sun had no disclosures to report.
Significant increases in the mastectomy rate among women with early breast cancer who were candidates for breast conservation surgery during a recent 14-year period in the United States were accompanied by increases in breast reconstruction and bilateral mastectomies, in a retrospective cohort study that tracked national trends in this group of women.
The results, based on outcomes of about 1.2 million women with early breast cancer in a national oncology outcomes database, “are generally consistent with trends noted in other state, regional, and national studies,” reported Dr. Kristy Kummerow of the division of surgical oncology and endocrine surgery, Vanderbilt University, Nashville, Tenn., and her associates. While they speculated on some of the reasons behind these findings, “further research is needed to understand patient, provider, policy, and social factors associated with these trends,” they concluded in the study, which was published online Nov. 19 in JAMA Surgery (doi:10.1001/jamasurg.2014.2895).
While the use of breast conservation surgery (BCS) as an alternative to mastectomy for early-stage breast cancer increased steadily after studies showed the two approaches had equal outcomes, and after endorsement by a National Institutes of Health Consensus Conference in 1990, the authors noted that there has been evidence that the trend is reversing.
Using data from the National Cancer Data Base, which collects outcomes data on about 70% of the patients diagnosed with cancer in the United States, they evaluated trends in mastectomies among adult women newly diagnosed with early (unilateral) breast cancer from January 1998 through December 2011. Women were included if TNM stage information was available, tumors were 5 cm or less with nine or fewer involved axillary lymph nodes based on clinical staging, and they underwent BCS (lumpectomy, segmental mastectomy, or re-excision of the biopsy site) or mastectomy (subcutaneous, total, modified radical or radical).
Over the 14-year period, among the approximately 1.2 million women who met the criteria, 64.5% had BCS and 35.5% had a mastectomy. The women who had a mastectomy were slightly younger (mean age 59.6 years vs. 61.6 years), and the proportion of racial and ethnic minorities was lower in this group.
The proportion of women eligible for BCS who underwent a mastectomy increased from 34.3% in 1998 to 37.8% in 2011, a statistically significant increase, “with steeper increases” seen in women who had node-negative and noninvasive disease, the authors reported. For the most recent 8-year period – 2003 to 2011 – the rate increased by 34%, “with the most notable rise in mastectomy rates occurring after 2006,” and the highest increases seen among women with clinically node-negative disease. Age and tumor size were “the most influential covariates,” with younger women “more likely to undergo mastectomy irrespective of tumor size, while in older women mastectomy was strongly associated with tumor size greater than 2 cm.”
During the period studied, there were significant increases in breast reconstruction and bilateral mastectomies among women who had mastectomies, which were secondary outcome measures. The proportion of women who underwent breast reconstruction increased from 11.6% in 1998 to 36.4% in 2011, and the proportion of women who had a bilateral mastectomy for unilateral disease increased from 1.9% to 11.2% during this period. The trend toward more reconstruction surgery could be due to 1998 legislation mandating insurance coverage of reconstructive surgery after mastectomy, the authors wrote.
Study limitations included missing clinical staging information for a large proportion of the women, no information on BRCA status or triple-negative tumors, and an inability to determine why the mastectomy was performed in individual cases, they noted.
None of the authors had disclosures to report. The study is based on work supported by the Office of Academic Affiliations, Department of Veterans Affairs, the VA National Quality Scholars Program, and with the use of facilities at the VA Tennessee Valley Healthcare System, Nashville.
Significant increases in the mastectomy rate among women with early breast cancer who were candidates for breast conservation surgery during a recent 14-year period in the United States were accompanied by increases in breast reconstruction and bilateral mastectomies, in a retrospective cohort study that tracked national trends in this group of women.
The results, based on outcomes of about 1.2 million women with early breast cancer in a national oncology outcomes database, “are generally consistent with trends noted in other state, regional, and national studies,” reported Dr. Kristy Kummerow of the division of surgical oncology and endocrine surgery, Vanderbilt University, Nashville, Tenn., and her associates. While they speculated on some of the reasons behind these findings, “further research is needed to understand patient, provider, policy, and social factors associated with these trends,” they concluded in the study, which was published online Nov. 19 in JAMA Surgery (doi:10.1001/jamasurg.2014.2895).
While the use of breast conservation surgery (BCS) as an alternative to mastectomy for early-stage breast cancer increased steadily after studies showed the two approaches had equal outcomes, and after endorsement by a National Institutes of Health Consensus Conference in 1990, the authors noted that there has been evidence that the trend is reversing.
Using data from the National Cancer Data Base, which collects outcomes data on about 70% of the patients diagnosed with cancer in the United States, they evaluated trends in mastectomies among adult women newly diagnosed with early (unilateral) breast cancer from January 1998 through December 2011. Women were included if TNM stage information was available, tumors were 5 cm or less with nine or fewer involved axillary lymph nodes based on clinical staging, and they underwent BCS (lumpectomy, segmental mastectomy, or re-excision of the biopsy site) or mastectomy (subcutaneous, total, modified radical or radical).
Over the 14-year period, among the approximately 1.2 million women who met the criteria, 64.5% had BCS and 35.5% had a mastectomy. The women who had a mastectomy were slightly younger (mean age 59.6 years vs. 61.6 years), and the proportion of racial and ethnic minorities was lower in this group.
The proportion of women eligible for BCS who underwent a mastectomy increased from 34.3% in 1998 to 37.8% in 2011, a statistically significant increase, “with steeper increases” seen in women who had node-negative and noninvasive disease, the authors reported. For the most recent 8-year period – 2003 to 2011 – the rate increased by 34%, “with the most notable rise in mastectomy rates occurring after 2006,” and the highest increases seen among women with clinically node-negative disease. Age and tumor size were “the most influential covariates,” with younger women “more likely to undergo mastectomy irrespective of tumor size, while in older women mastectomy was strongly associated with tumor size greater than 2 cm.”
During the period studied, there were significant increases in breast reconstruction and bilateral mastectomies among women who had mastectomies, which were secondary outcome measures. The proportion of women who underwent breast reconstruction increased from 11.6% in 1998 to 36.4% in 2011, and the proportion of women who had a bilateral mastectomy for unilateral disease increased from 1.9% to 11.2% during this period. The trend toward more reconstruction surgery could be due to 1998 legislation mandating insurance coverage of reconstructive surgery after mastectomy, the authors wrote.
Study limitations included missing clinical staging information for a large proportion of the women, no information on BRCA status or triple-negative tumors, and an inability to determine why the mastectomy was performed in individual cases, they noted.
None of the authors had disclosures to report. The study is based on work supported by the Office of Academic Affiliations, Department of Veterans Affairs, the VA National Quality Scholars Program, and with the use of facilities at the VA Tennessee Valley Healthcare System, Nashville.
FROM JAMA SURGERY
Key clinical point: Significantly more women with early breast cancer are undergoing mastectomy, despite being eligible for breast conservation surgery.
Major finding: The proportion of women with early breast cancer eligible for BCS who had a mastectomy increased from 34.3% in 1998 to 37.8% in 2011, a statistically significant increase.
Data source: A retrospective cohort study of trends during 1998-2011 in mastectomies among 1.2 million women with early breast cancer who were eligible for BCS and enrolled in the National Cancer Data Base.
Disclosures:None of the authors had disclosures to report. The study is based on work supported by the Office of Academic Affiliations, Department of Veterans Affairs , the VA National Quality Scholars Program, and with the use of facilities at the VA Tennessee Valley Healthcare System, Nashville.
A round-up of ASCO’s 2013-2014 guideline releases, updates, and endorsements
1. Follow-up care, surveillance, and secondary prevention measures for survivors of colorectal cancer1,2
Since 2006, ASCO has adopted a policy of endorsing clinical practice guidelines developed by others in order to increase the number of such guidelines available for ASCO membership. Recently, the society endorsed the guidelines for colon cancer follow-up created by the Cancer Care Ontario (CCO). These guidelines include surveillance recommendations that are very similar to the 2005 ASCO guidelines and the current NCCN guidelines, with a few minor differences. However, unlike NCCN and previous ASCO guidelines, the current guidelines include statements about secondary prevention, written survivorship plans for the patient’s other providers, and the futility of surveillance tests in patients who are not candidates for surgery or systemic therapy due to comorbid disease.
Click on the PDF icon at the top of this introduction to read the full article.
1. Follow-up care, surveillance, and secondary prevention measures for survivors of colorectal cancer1,2
Since 2006, ASCO has adopted a policy of endorsing clinical practice guidelines developed by others in order to increase the number of such guidelines available for ASCO membership. Recently, the society endorsed the guidelines for colon cancer follow-up created by the Cancer Care Ontario (CCO). These guidelines include surveillance recommendations that are very similar to the 2005 ASCO guidelines and the current NCCN guidelines, with a few minor differences. However, unlike NCCN and previous ASCO guidelines, the current guidelines include statements about secondary prevention, written survivorship plans for the patient’s other providers, and the futility of surveillance tests in patients who are not candidates for surgery or systemic therapy due to comorbid disease.
Click on the PDF icon at the top of this introduction to read the full article.
1. Follow-up care, surveillance, and secondary prevention measures for survivors of colorectal cancer1,2
Since 2006, ASCO has adopted a policy of endorsing clinical practice guidelines developed by others in order to increase the number of such guidelines available for ASCO membership. Recently, the society endorsed the guidelines for colon cancer follow-up created by the Cancer Care Ontario (CCO). These guidelines include surveillance recommendations that are very similar to the 2005 ASCO guidelines and the current NCCN guidelines, with a few minor differences. However, unlike NCCN and previous ASCO guidelines, the current guidelines include statements about secondary prevention, written survivorship plans for the patient’s other providers, and the futility of surveillance tests in patients who are not candidates for surgery or systemic therapy due to comorbid disease.
Click on the PDF icon at the top of this introduction to read the full article.
Early Cancer Detection Helps Underserved Women
Nearly 60,000 breast and cervical cancers were caught and diagnosed between 1991 and 2011 through the CDC’s National Breast and Cervical Cancer Early Detection Program (NBCCEDP).
The NBCCEDP is the only nationwide cancer screening program serving all 50 states, the District of Columbia, 5 U.S. territories, and 11 tribes or tribal organizations. In its first 20 years, the program served > 4.3 million women who might not otherwise have received preventive screenings. More than 10.7 million received mammograms and Pap tests.
More than 90% of the women in whom cancerous or precancerous lesions were detected received appropriate and timely follow-up care, according to a CDC report, published in an August 2014 supplement to Cancer. The supplement, National Breast and Cervical Cancer Early Detection Program: Two Decades of Service to Underserved Women, contains 13 new papers that evaluate aspects of the NBCCEDP, showing “consistent value” in the program, the CDC says, even beyond its original purpose of detecting cancers in underserved women.
This is the first time detailed information has been published about the program’s screening activities and other interventions. Partnerships with national organizations, community-based organizations, government agencies, tribes, health care systems, and professional organizations have played a “critical role” in achieving NBCCEDP goals, the CDC says.
Nearly 60,000 breast and cervical cancers were caught and diagnosed between 1991 and 2011 through the CDC’s National Breast and Cervical Cancer Early Detection Program (NBCCEDP).
The NBCCEDP is the only nationwide cancer screening program serving all 50 states, the District of Columbia, 5 U.S. territories, and 11 tribes or tribal organizations. In its first 20 years, the program served > 4.3 million women who might not otherwise have received preventive screenings. More than 10.7 million received mammograms and Pap tests.
More than 90% of the women in whom cancerous or precancerous lesions were detected received appropriate and timely follow-up care, according to a CDC report, published in an August 2014 supplement to Cancer. The supplement, National Breast and Cervical Cancer Early Detection Program: Two Decades of Service to Underserved Women, contains 13 new papers that evaluate aspects of the NBCCEDP, showing “consistent value” in the program, the CDC says, even beyond its original purpose of detecting cancers in underserved women.
This is the first time detailed information has been published about the program’s screening activities and other interventions. Partnerships with national organizations, community-based organizations, government agencies, tribes, health care systems, and professional organizations have played a “critical role” in achieving NBCCEDP goals, the CDC says.
Nearly 60,000 breast and cervical cancers were caught and diagnosed between 1991 and 2011 through the CDC’s National Breast and Cervical Cancer Early Detection Program (NBCCEDP).
The NBCCEDP is the only nationwide cancer screening program serving all 50 states, the District of Columbia, 5 U.S. territories, and 11 tribes or tribal organizations. In its first 20 years, the program served > 4.3 million women who might not otherwise have received preventive screenings. More than 10.7 million received mammograms and Pap tests.
More than 90% of the women in whom cancerous or precancerous lesions were detected received appropriate and timely follow-up care, according to a CDC report, published in an August 2014 supplement to Cancer. The supplement, National Breast and Cervical Cancer Early Detection Program: Two Decades of Service to Underserved Women, contains 13 new papers that evaluate aspects of the NBCCEDP, showing “consistent value” in the program, the CDC says, even beyond its original purpose of detecting cancers in underserved women.
This is the first time detailed information has been published about the program’s screening activities and other interventions. Partnerships with national organizations, community-based organizations, government agencies, tribes, health care systems, and professional organizations have played a “critical role” in achieving NBCCEDP goals, the CDC says.
VIDEO: An easy way to improve breast biopsy practices
SAN FRANCISCO – Surgeons improve if they know they are behind the curve, according to Dr. Judy A. Tjoe, a breast cancer surgeon with Milwaukee-based Aurora Health Care.
She and her colleagues used that principle to significantly increase Aurora’s use of minimally invasive breast biopsies, the gold standard to diagnose breast cancer.
Although Dr. Tjoe and the system’s other three dedicated breast surgeons were using MIBB as appropriate, they found that 9 of 42 general surgeons (21%) were not, opting instead for open biopsies.
All it took to fix the problem was letting those surgeons know that minimally invasive breast biopsies was the preferred method, and that most of their peers were using it.
In a video interview at the American College of Surgeons Clinical Congress, Dr. Tjoe, also chair of Aurora’s quality committee for breast cancer care, explained why that message was so powerful, and how, in an era of pay for performance, the project is a model for improving health care without punitive measures.
The video associated with this article is no longer available on this site. Please view all of our videos on the MDedge YouTube channel
SAN FRANCISCO – Surgeons improve if they know they are behind the curve, according to Dr. Judy A. Tjoe, a breast cancer surgeon with Milwaukee-based Aurora Health Care.
She and her colleagues used that principle to significantly increase Aurora’s use of minimally invasive breast biopsies, the gold standard to diagnose breast cancer.
Although Dr. Tjoe and the system’s other three dedicated breast surgeons were using MIBB as appropriate, they found that 9 of 42 general surgeons (21%) were not, opting instead for open biopsies.
All it took to fix the problem was letting those surgeons know that minimally invasive breast biopsies was the preferred method, and that most of their peers were using it.
In a video interview at the American College of Surgeons Clinical Congress, Dr. Tjoe, also chair of Aurora’s quality committee for breast cancer care, explained why that message was so powerful, and how, in an era of pay for performance, the project is a model for improving health care without punitive measures.
The video associated with this article is no longer available on this site. Please view all of our videos on the MDedge YouTube channel
SAN FRANCISCO – Surgeons improve if they know they are behind the curve, according to Dr. Judy A. Tjoe, a breast cancer surgeon with Milwaukee-based Aurora Health Care.
She and her colleagues used that principle to significantly increase Aurora’s use of minimally invasive breast biopsies, the gold standard to diagnose breast cancer.
Although Dr. Tjoe and the system’s other three dedicated breast surgeons were using MIBB as appropriate, they found that 9 of 42 general surgeons (21%) were not, opting instead for open biopsies.
All it took to fix the problem was letting those surgeons know that minimally invasive breast biopsies was the preferred method, and that most of their peers were using it.
In a video interview at the American College of Surgeons Clinical Congress, Dr. Tjoe, also chair of Aurora’s quality committee for breast cancer care, explained why that message was so powerful, and how, in an era of pay for performance, the project is a model for improving health care without punitive measures.
The video associated with this article is no longer available on this site. Please view all of our videos on the MDedge YouTube channel
AT THE AMERICAN COLLEGE OF SURGEONS CLINICAL CONGRESS
Meditation, yoga earn high marks as supportive care during breast cancer treatment
Meditation, yoga, and relaxation with imagery can be recommended as evidence-based supportive care options during breast cancer treatment, according to a data review published in the Journal of the National Cancer Institute Monographs.
A review of randomized controlled clinical trials has provided researchers with strong evidence that certain behavioral therapies for mood improvement, depression, and anxiety can be useful as supportive care in women receiving standard breast cancer treatment (J. Natl. Cancer Inst. Monogr. 2014;50:346-58).
To determine which therapies had an effect during breast cancer treatment, the researchers organized a review of randomized controlled trials designed to assess the safety and effectiveness of more than 80 different intervention/modality combinations.
The investigators, led by Heather Greenlee, Ph.D., used a set of nine biomedical publication databases to find 203 randomized controlled clinical trials among breast cancer patients that tested complementary therapies together with standard cancer care – defined as surgery, chemotherapy, radiation therapy, and hormonal therapy.
A modified version of the U.S. Preventive Services Task Force grading system was used to develop and evaluate the effectiveness of the therapies, which were ranked into A, B, C, D, and H grades based on their evidence of benefit.
‘A’ grades were given to meditation, yoga, and relaxation with imagery, which were associated with mood improvement in the context of depression and anxiety during treatment for breast cancer. Music therapy was given a B grade for stress reduction.
C grades were assigned to 32 treatments that had weaker evidence of benefit, and 138 therapies were deemed to have insufficient evidence to form recommendations. Nine therapies were given a D grade, meaning they did not appear to have any effect on cancer treatment.
Only one intervention was given an H grade, meaning it was identified as potentially harmful: acetyl-L-carnitine, used for the prevention of taxane-induced neuropathy,was found to increase neuropathy.
Though the recommended therapies will not work for everyone, the guidelines should at least help clinicians and patients create a dialogue about treatment options, regardless of what the patient ultimately chooses, wrote Dr. Greenlee of Columbia University’s Mailman School of Public Health, together with colleagues at the Herbert Irving Comprehensive Cancer Center, the M.D. Anderson Cancer Center, the University of Michigan, the Memorial Sloan Kettering Cancer Center, and other U.S. and Canadian institutions.
Although A and B grade treatments will be recommended by the Society for Integrative Oncology as secondary therapies for breast cancer patients, the authors stressed that more research will be needed to identify and improve newer therapy options for breast cancer patients.
“Given the limited number of Grade A and Grade B recommendations, clinicians should engage patients in shared decision making using evidence-based projected benefits and harms that reflect patient values and preferences, as well as acknowledge their clinical prognosis,” the researchers wrote.
The authors had no relevant financial conflicts of interest to disclose.
Meditation, yoga, and relaxation with imagery can be recommended as evidence-based supportive care options during breast cancer treatment, according to a data review published in the Journal of the National Cancer Institute Monographs.
A review of randomized controlled clinical trials has provided researchers with strong evidence that certain behavioral therapies for mood improvement, depression, and anxiety can be useful as supportive care in women receiving standard breast cancer treatment (J. Natl. Cancer Inst. Monogr. 2014;50:346-58).
To determine which therapies had an effect during breast cancer treatment, the researchers organized a review of randomized controlled trials designed to assess the safety and effectiveness of more than 80 different intervention/modality combinations.
The investigators, led by Heather Greenlee, Ph.D., used a set of nine biomedical publication databases to find 203 randomized controlled clinical trials among breast cancer patients that tested complementary therapies together with standard cancer care – defined as surgery, chemotherapy, radiation therapy, and hormonal therapy.
A modified version of the U.S. Preventive Services Task Force grading system was used to develop and evaluate the effectiveness of the therapies, which were ranked into A, B, C, D, and H grades based on their evidence of benefit.
‘A’ grades were given to meditation, yoga, and relaxation with imagery, which were associated with mood improvement in the context of depression and anxiety during treatment for breast cancer. Music therapy was given a B grade for stress reduction.
C grades were assigned to 32 treatments that had weaker evidence of benefit, and 138 therapies were deemed to have insufficient evidence to form recommendations. Nine therapies were given a D grade, meaning they did not appear to have any effect on cancer treatment.
Only one intervention was given an H grade, meaning it was identified as potentially harmful: acetyl-L-carnitine, used for the prevention of taxane-induced neuropathy,was found to increase neuropathy.
Though the recommended therapies will not work for everyone, the guidelines should at least help clinicians and patients create a dialogue about treatment options, regardless of what the patient ultimately chooses, wrote Dr. Greenlee of Columbia University’s Mailman School of Public Health, together with colleagues at the Herbert Irving Comprehensive Cancer Center, the M.D. Anderson Cancer Center, the University of Michigan, the Memorial Sloan Kettering Cancer Center, and other U.S. and Canadian institutions.
Although A and B grade treatments will be recommended by the Society for Integrative Oncology as secondary therapies for breast cancer patients, the authors stressed that more research will be needed to identify and improve newer therapy options for breast cancer patients.
“Given the limited number of Grade A and Grade B recommendations, clinicians should engage patients in shared decision making using evidence-based projected benefits and harms that reflect patient values and preferences, as well as acknowledge their clinical prognosis,” the researchers wrote.
The authors had no relevant financial conflicts of interest to disclose.
Meditation, yoga, and relaxation with imagery can be recommended as evidence-based supportive care options during breast cancer treatment, according to a data review published in the Journal of the National Cancer Institute Monographs.
A review of randomized controlled clinical trials has provided researchers with strong evidence that certain behavioral therapies for mood improvement, depression, and anxiety can be useful as supportive care in women receiving standard breast cancer treatment (J. Natl. Cancer Inst. Monogr. 2014;50:346-58).
To determine which therapies had an effect during breast cancer treatment, the researchers organized a review of randomized controlled trials designed to assess the safety and effectiveness of more than 80 different intervention/modality combinations.
The investigators, led by Heather Greenlee, Ph.D., used a set of nine biomedical publication databases to find 203 randomized controlled clinical trials among breast cancer patients that tested complementary therapies together with standard cancer care – defined as surgery, chemotherapy, radiation therapy, and hormonal therapy.
A modified version of the U.S. Preventive Services Task Force grading system was used to develop and evaluate the effectiveness of the therapies, which were ranked into A, B, C, D, and H grades based on their evidence of benefit.
‘A’ grades were given to meditation, yoga, and relaxation with imagery, which were associated with mood improvement in the context of depression and anxiety during treatment for breast cancer. Music therapy was given a B grade for stress reduction.
C grades were assigned to 32 treatments that had weaker evidence of benefit, and 138 therapies were deemed to have insufficient evidence to form recommendations. Nine therapies were given a D grade, meaning they did not appear to have any effect on cancer treatment.
Only one intervention was given an H grade, meaning it was identified as potentially harmful: acetyl-L-carnitine, used for the prevention of taxane-induced neuropathy,was found to increase neuropathy.
Though the recommended therapies will not work for everyone, the guidelines should at least help clinicians and patients create a dialogue about treatment options, regardless of what the patient ultimately chooses, wrote Dr. Greenlee of Columbia University’s Mailman School of Public Health, together with colleagues at the Herbert Irving Comprehensive Cancer Center, the M.D. Anderson Cancer Center, the University of Michigan, the Memorial Sloan Kettering Cancer Center, and other U.S. and Canadian institutions.
Although A and B grade treatments will be recommended by the Society for Integrative Oncology as secondary therapies for breast cancer patients, the authors stressed that more research will be needed to identify and improve newer therapy options for breast cancer patients.
“Given the limited number of Grade A and Grade B recommendations, clinicians should engage patients in shared decision making using evidence-based projected benefits and harms that reflect patient values and preferences, as well as acknowledge their clinical prognosis,” the researchers wrote.
The authors had no relevant financial conflicts of interest to disclose.
FROM THE JOURNAL OF THE NATIONAL CANCER INSTITUTE MONOGRAPHS